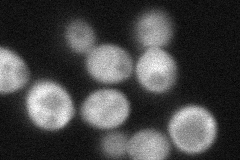
YEL071W
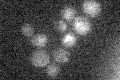
YEL071W

View description
D-lactate dehydrogenase, part of the retrograde regulon which consists of genes whose expression is stimulated by damage to mitochondria and reduced in cells grown with glutamate as the sole nitrogen source, located in the cytoplasm
Localization:
Intensity:
Fold change:
Significance:
-
C’ GFP library in SD

below threshold16.46 -
N' NOP1pr-GFP in SD

cytosol154.906 -
N' TEF2pr-mCherry in SD

cytosol230.667 -
N' NATIVEpr-GFP in SD

cytosol18.1238 -
N' TEF2pr-VC and Cyto-VN in SD
cytosol73.8906 -
C’ GFP library in SD+DTT

cytosol16.61No -
C’ GFP library in SD+H2O2

cytosol14.640.88No -
C’ GFP library in Starvation Media
cytosol14.020.85No -
C’ GFP library on the background of Pup2-DaMP

below threshold -
C’ GFP library on the background of CCT mutant

below threshold18.43671.11956No
